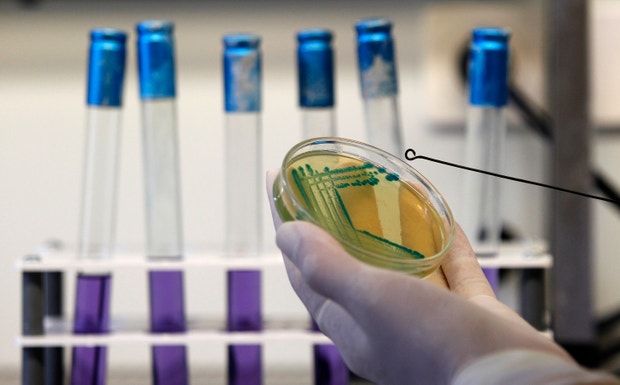

País
Autoridades apontam Adubos de Portugal como origem de surto de legionella
Os resultados das análises a torres de refrigeração situam na ADP Fertilizantes a origem do surto de legionella em Vila Franca de Xira, responsável por dez mortes. As bactérias encontradas em doentes são semelhantes à extirpe que foi detetada na fábrica.
Foto: Stoyan Nenov, Reuters
Paulo Macedo quis dar ênfase à resposta das unidades hospitalares, que "trataram mais de 300 pneumonias".
Concluído o último encontro da task force formada para o acompanhamento dos casos de legionella em Vila Franca de Xira, o ministro da Saúde declarou o surto extinto, sem excluir, no entanto, eventuais mortes associadas à bactéria nos próximos dias.

Foto: António Cotrim, Lusa
Segundo Paulo Macedo, resultados laboratoriais vieram reforçar informação anteriormente apurada que apontava para um nexo entre as bactérias encontradas numa torre de refrigeração da empresa Adubos de Portugal e as amostras recolhidas em doentes.
Presente na mesma conferência de imprensa, o diretor-geral da Saúde, Francisco George, adiantou que os resultados dos exames a torres de refrigeração de Vila Franca de Xira vão seguir para o Ministério Público.